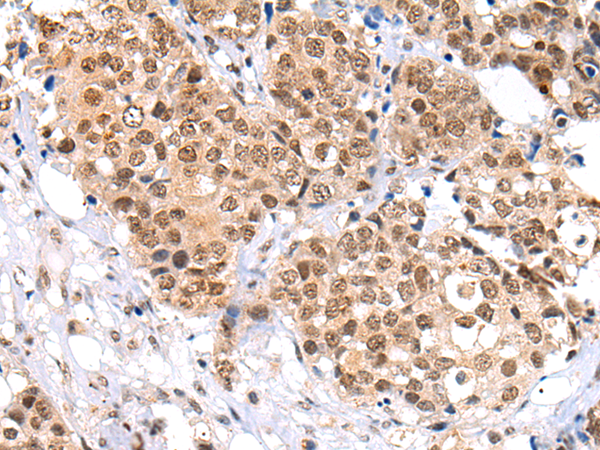
一抗

技術規(guī)格
|
Background: |
This gene encodes a protein containing KELCH-1 like domains, as well as a BTB/POZ domain. Kelch-like ECH-associated protein 1 interacts with NF-E2-related factor 2 in a redox-sensitive manner and the dissociation of the proteins in the cytoplasm is followed by transportation of NF-E2-related factor 2 to the nucleus. This interaction results in the expression of the catalytic subunit of gamma-glutamylcysteine synthetase. Two alternatively spliced transcript variants encoding the same isoform have been found for this gene. |
|
Applications: |
ELISA, IHC |
|
Name of antibody: |
KEAP1 |
|
Immunogen: |
Synthetic peptide of human KEAP1 |
|
Full name: |
kelch-like ECH-associated protein 1 |
|
Synonyms: |
INrf2; KLHL19 |
|
SwissProt: |
Q14145 |
|
ELISA Recommended dilution: |
2000-5000 |
|
IHC positive control: |
Human thyroid cancer and Human esophagus cancer |
|
IHC Recommend dilution: |
25-100 |


 購物車
購物車 幫助
幫助
 021-54845833/15800441009
021-54845833/15800441009